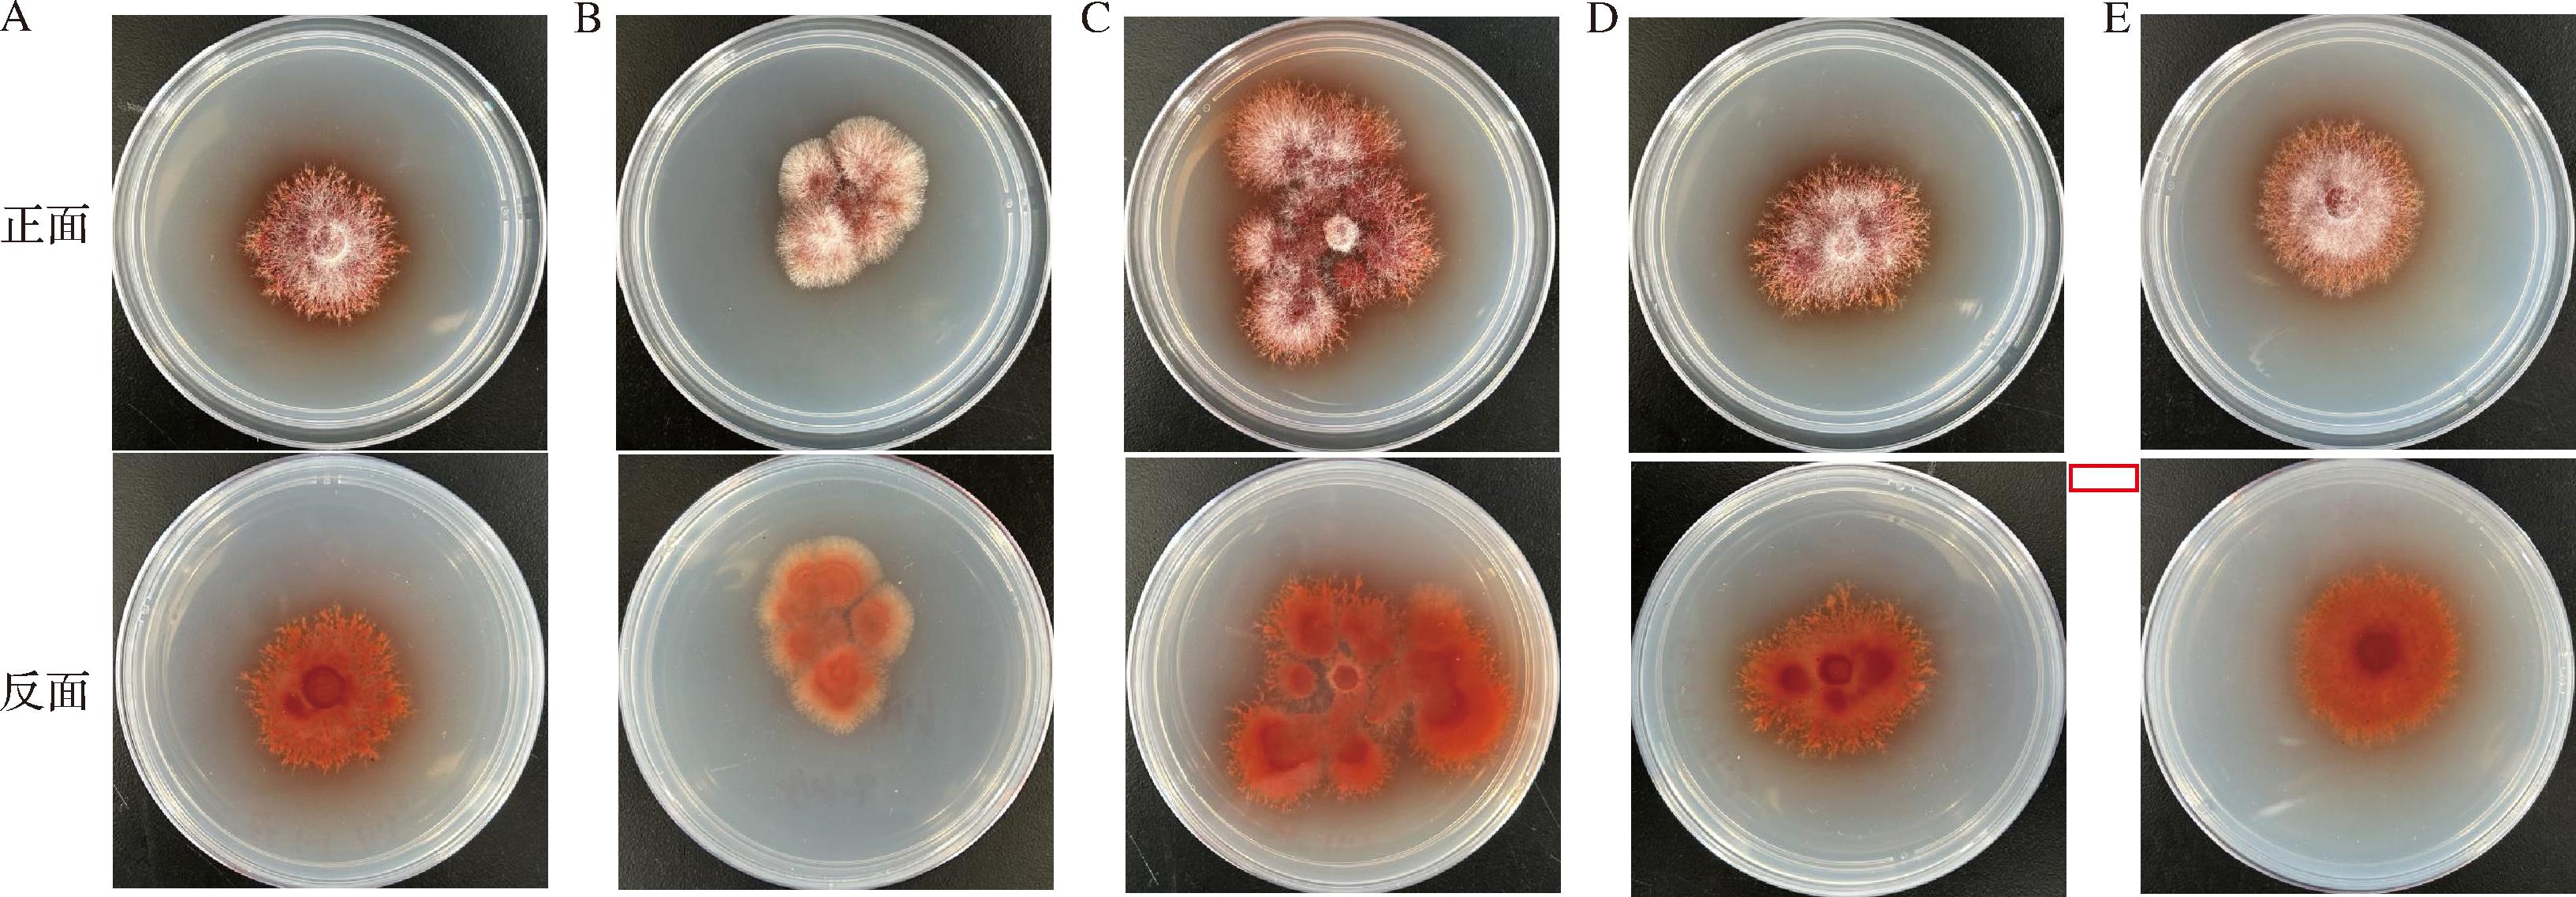
width=598,height=208,dpi=110
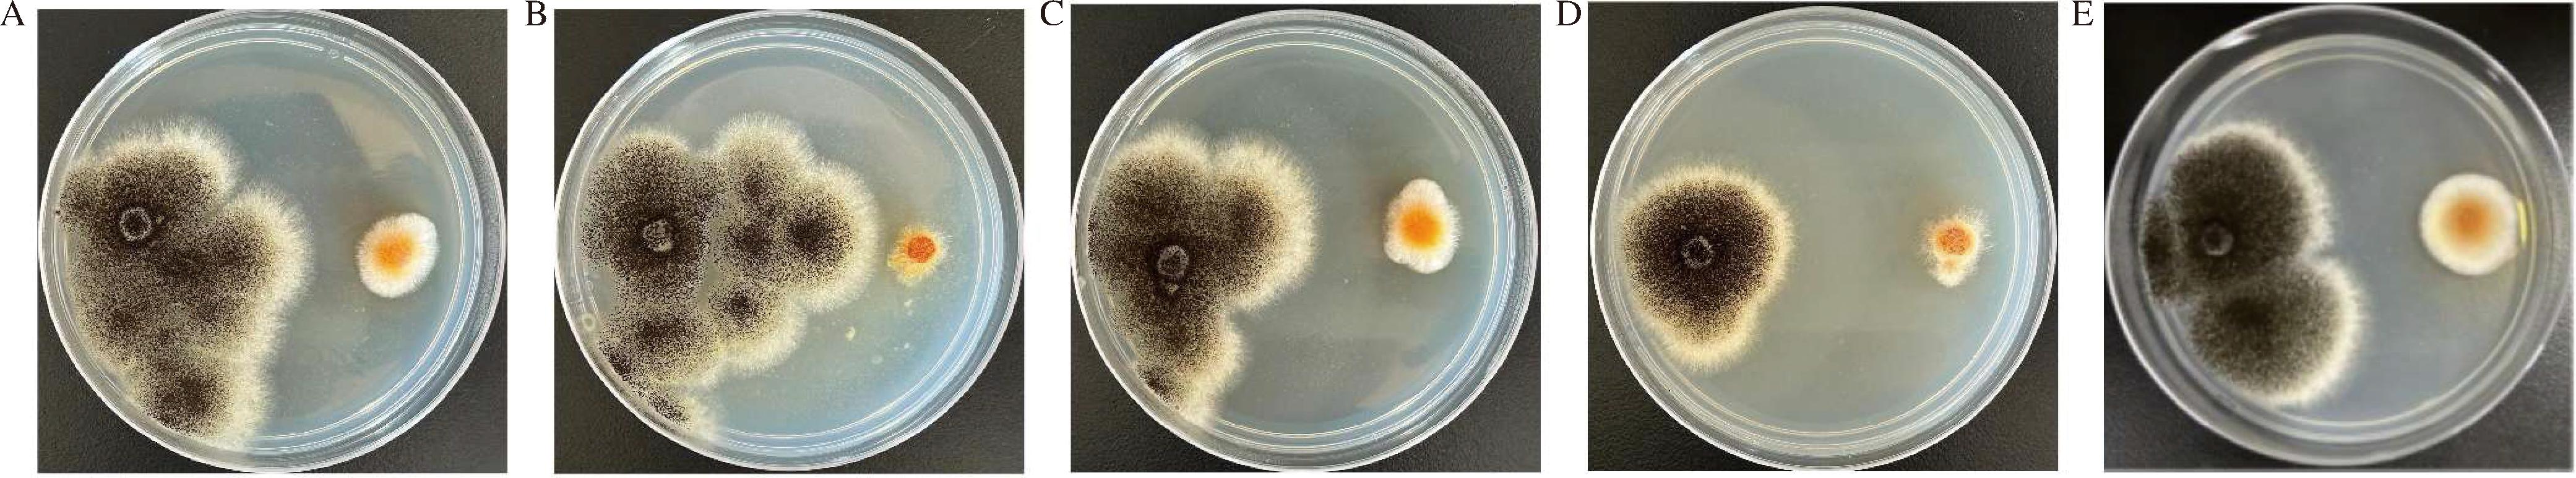
width=736,height=136,dpi=110
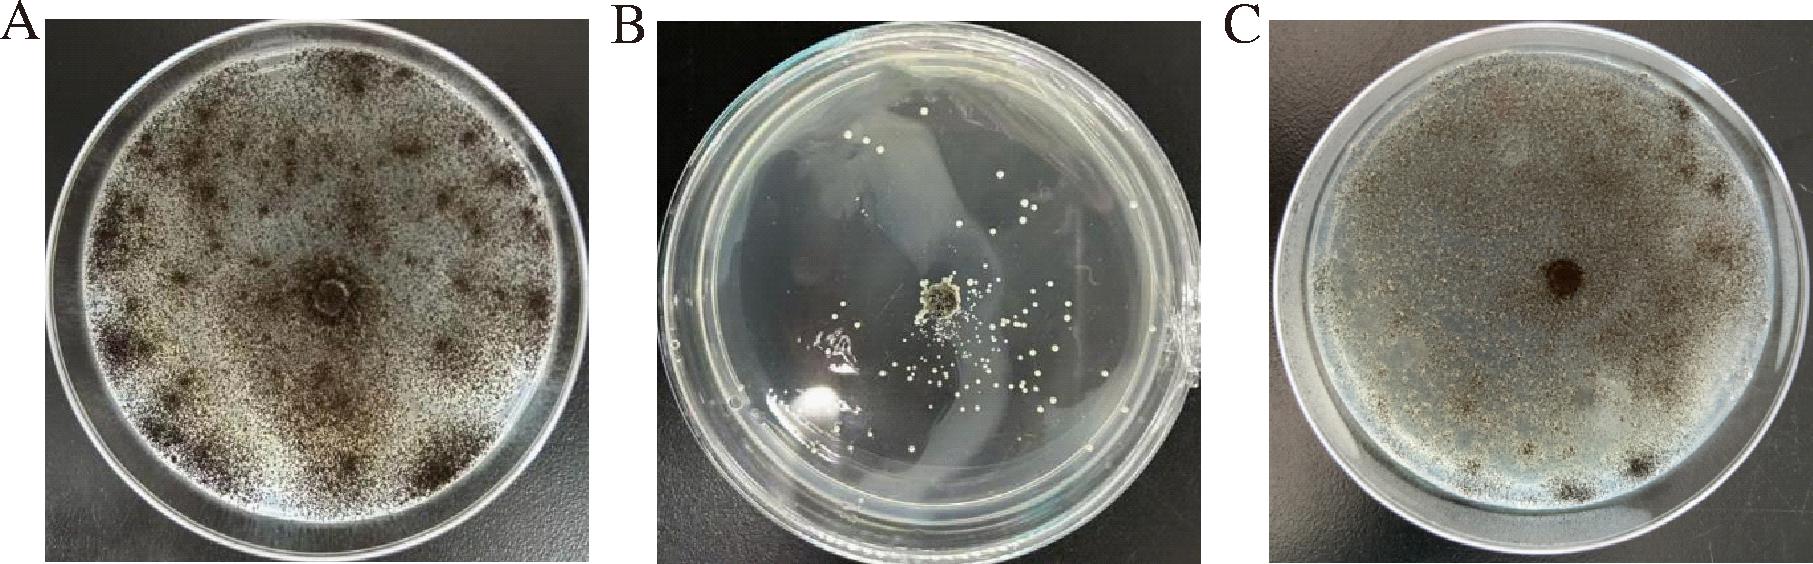
width=332,height=103,dpi=110

红曲菌属真菌界(Eumycophyta)、子囊菌门(Ascomycota)、真子囊菌纲(Euascomycetes)、散子囊菌目(Eurotiales)、红曲菌科(Monascaceae)、红曲属(Monascus),是一类小型丝状腐生真菌。红曲霉菌落初为白色,随着生长,逐渐变为紫红色或淡粉色等,主要有紫色红曲霉(Monascus purpureus)、红色红曲霉(Monascus ruber)和丛毛红曲霉(Monascus pilosus)等[1]。红曲霉是我国最早用于食品加工的有益真菌之一,其大米发酵的产品被称为红曲米,在我国已有1 000多年的历史。
红曲霉在发酵过程中可以产生丰富的次生代谢产物,包括莫纳克林K、γ-氨基丁酸(γ-aminobutyric acid, GABA)、麦角甾醇、酚酸类等,这些代谢产物具有不同的药理活性,如抗菌、抗炎、调节血脂、抗动脉粥样硬化、降血压等作用[2]。20世纪70年代末,ENDO[3]首次从M.ruber中分离出具有降低胆固醇活性的代谢产物莫纳克林K,其作用机制为抑制胆固醇合成过程中的羟甲基戊二酰辅酶A(hydroxymethylglutaryl coenzyme A,HMG-CoA)还原酶的活性[4]。GABA是红曲霉代谢过程中产生的另一种主要活性物质,为神经系统中主要的抑制性神经递质,对人体血压的调控有着重要的影响[5]。
红曲霉的抗菌活性从古至今都仍在研究,早在1991年,NOZAKI等[6]从安卡红曲霉(Monascus anka)的发酵培养液中分离出一种抗菌活性物质。刘书渊等[7]从M.ruber Mr-1次级代谢产物中分离得3个黄酮类和1个萜类化合物,这些化合物对金黄色葡萄球菌(Staphylococcus aureus)和李斯特菌均有抑制作用。而红曲色素氨基酸衍生物具有抗黑曲霉菌(Aspergillus niger)、桔青霉和白色念珠菌的抑菌活性[8]。此外,还发现红曲橙色素Rubropunctatin和Monascorubrin对细菌、酵母和丝状真菌具有抑制活性[9]。进一步研究表明,红曲中具有α-亚麻酸、邻苯二甲酸二丁酯和亚油酸等多种抑菌活性物质,因此,红曲对细菌和真菌等不同菌种均有不同程度的抑菌作用[10]。A.niger是常见的引起人体发病的条件致病性真菌,常见于免疫系统受损的人群,其发病因素包括长期使用免疫抑制剂、器官移植、化疗、恶性肿瘤等[11]。而红曲霉是一种重要的药食同源性真菌,目前有关红曲霉抑制A.niger的研究较少,因此,本文从红曲产品中分离、鉴定红曲霉,测定其抑菌活性,并对优势菌株进行代谢产物研究,以期探究发挥抗菌作用的活性物质种类。
1 材料与方法
1.1 材料
1.1.1 实验样品
红曲米(安徽宝栀堂生物科技有限公司)、红曲米和红曲粉(福建古田县红鑫酒粬有限公司)。
1.1.2 受试菌株
抑菌实验所用菌株为S.aureus、大肠杆菌(Escherichia coli)和A.niger,以上菌株均由宜春学院(江西省作物生长发育调控重点实验室)实验室保存。
1.1.3 试剂
植物基因组DNA提取试剂盒,天根生化科技(北京)有限公司;甲醇、无水乙醇和75%(体积分数)乙醇等试剂均为分析纯,西陇科学股份有限公司;乙酸乙酯为工业级,安徽颉创生物科技有限公司;蛋白胨、酵母提取物、琼脂等生化试剂,上海生工生物工程有限公司。
1.1.4 培养基
PDA培养基的配制:马铃薯200 g/L,葡萄糖20 g/L,pH 7.2~7.4,121 ℃灭菌30 min。(固体PDA培养基加入琼脂 15~20 g/L)。
LB培养基配制:酵母提取物5 g/L,胰蛋白胨10 g/L,氯化钠10 g/L,pH 7.2~7.4,121 ℃灭菌30 min(固体LB培养基加入琼脂15~20 g/L)。
1.2 仪器与设备
Eclipse E200正置生物显微镜,日本尼康公司;LRH-250生化培养箱,上海一恒科学仪器有限公司;BCM-1300A生物洁净工作台,苏净集团苏州安泰空气技术有限公司;YXQ-LS-50SII立式压力蒸气灭菌器,上海博迅实业有限公司医疗设备厂;202-1AB型电热恒温干燥箱,天津市泰斯特仪器有限公司;ZWY-100H恒温培养振荡器,上海智城分析仪器制造有限公司;DLK-5003快速低温冷却循环机,宁波新芝生物科技股份有限公司;YTLG-10A真空冷冻干燥机,上海叶拓科技有限公司。
1.3 实验方法
1.3.1 红曲霉的分离纯化
1.3.1.1 红曲霉活化
将2种红曲米分别放入研钵内研磨成粉,红曲粉则直接使用。称取5 g红曲样品,置于含有95 mL无菌生理盐水的带玻璃珠的150 mL锥形瓶中,在摇床上振荡30 min使红曲霉菌种活化。
1.3.1.2 红曲霉的纯化培养
采用梯度稀释法,将已活化的红曲霉菌液接种到PDA平板上, 28 ℃培养3~4 d,待培养基上长出肉眼可见大小的菌落时,用无菌接种环挑取单个菌落转接至新的PDA平板,经过反复分离纯化,得到具有红曲菌基本特征的较纯菌株。
1.3.2 优势菌株的筛选
1.3.2.1 病原菌活化
将保存好的病原细菌(E.coli和S.aureus)分别转移到新配制的LB固体培养基中培养1 d,用接种环蘸取适量培养好的病原细菌,分别接种至含有10 mL液体LB培养基的50 mL离心管中,于37 ℃、180 r/min摇床振荡培养24 h,培养完毕后取适量菌液调OD600值至0.6备用;病原真菌(A.niger)用5 mm打孔器打菌饼,转接到新的PDA培养基中培养3~5 d。
1.3.2.2 拮抗病原真菌
以A.niger为指示菌,采用两点对峙法检测不同材料中提取出的红曲霉对病原真菌的抑菌活性,筛选出抑菌效果强的优势菌株进行后续代谢产物的研究。在装有PDA培养基的培养皿两端相距4 cm处分别接种大小相同的A.niger和红曲霉菌的菌饼,以单独接种A.niger的平板作对照组,28 ℃培养,设置3次重复。待对照组A.niger基本长满培养皿后,测量对照组和处理组中A.niger的菌落半径,筛选出对A.niger抑制效果较好的红曲霉菌株。
1.3.2.3 拮抗病原细菌
采用琼脂板打孔法,检测不同材料中提取出的红曲霉对病原细菌的抑菌活性,取指示病原菌菌液30 μL(S.aureus, E.coli OD600值为0.6)均匀涂布在LB琼脂板上,用无菌打孔器(7 mm)在LB平板上打孔后,孔中加入发酵液50 μL,37 ℃孵育24 h,做2次重复,观察并测定抑菌圈大小。
1.3.3 优势菌株的鉴定
1.3.3.1 形态学鉴定
在无菌条件下,使用打孔器在分离纯化后得到的菌株上打取直径为5 mm的菌饼,接种到新的PDA培养基中培养4~7 d后,25 ℃下培养7 d,观察并记录菌落特征。菌落形态特征包括菌落大小、颜色、质地、厚薄、纹饰、边缘形态等。
1.3.3.2 分子生物学鉴定
对抑菌活性最强的菌株进行分子鉴定,采用植物基因组DNA提取试剂盒提取总DNA,以ITS1(TCCGTAGGTGAACCTGCGG)和ITS4-R(TCCTCCGCTTATTGATATGC)为引物进行PCR扩增,本实验PCR扩增体系为25 μL,正反向引物各1 μL,Taq酶12.5 μL,DNA模板1 μL,ddH2O 9.5 μL,反应参数为94 ℃变性30 s,57 ℃退火30 s,30个循环,72 ℃延伸90 s,72 ℃终延伸10 min。PCR 扩增产物由生工生物工程(上海)股份有限公司测序。扩增产物测序后登录NCBI进行BLAST检索,初步确认菌所属的种类,再和已知种属的其他菌株比对分析并构建系统发育树。
1.3.4 内生菌代谢产物的提取
取出保藏好的红曲霉菌株,挑取少量菌种到新鲜PDA培养基上划线并于28 ℃恒温活化3~5 d。活化后在无菌操作下从长满目标菌丝的平板中用5 mm打孔器打菌饼,立即置于含有300 mL PDA培养基1 L锥形瓶中,每瓶放6块菌饼,共接20瓶,然后在28 ℃的恒温振荡培养箱中,以180 r/min 的条件下振荡培养 14 d,得到真菌发酵液,并定时观察在发酵期间是否被污染。
发酵结束后将发酵液抽滤,分离滤液和菌丝,先将滤液转移至大分液漏斗中,加入等体积的乙酸乙酯,进行振荡萃取,每次萃取时间不少于30 min,共萃取3次,将萃取后的乙酸乙酯合并,再次旋蒸减压浓缩,干燥后称重,获得乙酸乙酯粗提物;菌丝加入2倍体积的甲醇超声振荡破碎菌丝体,然后放入4 ℃冰箱冷藏一晚,真空抽滤,收集滤液再次旋蒸减压浓缩,干燥后称重,获得甲醇粗提物并放入-20 ℃冰箱保存,备用做后续活性测定及成分检测。
1.3.5 内生菌代谢产物的抑菌活性
采用菌丝生长速率抑制法,将2种代谢粗提物用甲醇溶解成20 mg/mL的溶液,将1 mL代谢物处理液加入到灭菌的培养皿中,然后倒入9 mL已冷却至50 ℃左右的 PDA 培养基,充分摇匀,冷却后,将直径5 mm的A.niger菌块(28 ℃培养48 h)接种于该平板中央,盖上皿盖,以加等体积溶剂甲醇的PDA 培养基作空白对照,试验平板和对照平板均在28 ℃暗处培养3~5 d,并观察A.niger的生长情况,待对照组平板快要生长至平板边缘时测量各平板生长情况,做3次重复。并采用微量肉汤稀释法,测定红曲霉H3-1对A.niger的最小抑菌浓度(minimum inhibitory concentration,MIC)和最低杀菌浓度(minimum bactericidal concentration,MBC)。
采用十字交叉法测量记录各组菌落直径,计算发酵处理液对A.niger的菌丝生长抑制率,抑菌率按公式(1)计算:
抑菌率![]()
(1)
1.3.6 代谢产物成分测定
1.3.6.1 样品预处理
将1.3.5节中提取的代谢物样品冻干并研磨,称取(40±1) mg到离心管中,加入体积分数为80%甲醇水内标提示剂500 μL,涡旋3 min,使样品完全悬浮,将离心管放入液氮中速冻5 min,取出干冰上解冻5 min,再冰上解冻5 min(防止温差过大导致管盖爆开,样本喷出),涡旋2 min混匀,重复放入液氮、解冻、涡旋3次。在4 ℃条件下,12 000 r/min离心10 min,移取上清液300 μL到新的离心管中,并在-20 ℃冰箱中静置30 min。最后在4 ℃条件下,12 000 r/min再离心10 min,移取上清液200 μL到进样瓶内衬管中,用于上机分析。
1.3.6.2 色谱条件
Wsters ACQUITY Premire HSS T3 Column(2.1 mm×100 mm,1.8 μm),柱温选择40 ℃;流动相A相为超纯水(加入体积分数为0.1%的甲酸),B相为乙腈(加入体积分数为0.1%的甲酸);洗脱梯度为:0.00 min B相比例为5%,2.00 min B相比例为20%,5.00 min 时B相比例为60%,6 min 时增加到99%,并维持99%1.5 min,7.6~10 min B相比例降为5%;流速0.4 mL/min,进样量4 μL。
1.3.6.3 质谱条件
离子化电压3 500 V(正离子模式)/-3 200 V(负离子模式);鞘气和辅助气分别设置为30、5 psi;离子传输管温度为320 ℃;雾化温度为300 ℃;MS1质量扫描范围为75~1 000 m/z,分辨率为35 000 Hz;MS2质量扫描范围为75~1 000 m/z,分辨率为17 500 Hz。
1.4 数据处理
质谱下机原始数据经过ProteoWizard转换为mzML格式,采用XCMS程序进行峰提取,对齐,保留时间校正。对各组样本中缺失率高于50%的峰进行过滤,并对空白值进行K-最近邻(K-nearest neighbors, KNN)填充+1/5最小值(空白值高于50%采用1/5最小值填充,空白值低于50%采用KNN填充),采用支持向量回归(support vector regression,SVR)方法对峰面积进行校正。校正筛选后的峰通过检索实验室自建数据库、整合公共库、预测库以及metDNA方法进行代谢物鉴定。最后提取鉴定综合打分0.5分以上且质量控制(quality control,QC)样本变异系数(coefficient of variation,CV)值小于0.3的物质,再进行正、负模式合并(保留定性等级最高且CV值最小的物质),即得。采用主成分分析法(principal component analsis, PCA)、聚类热图和化合物分类等,根据变量重要性投影(variable importance in projection,VIP)值结合独立样本t检验,即VIP值>1且P<0.05筛选组间的差异代谢物,并对差异倍数以2为底取对数(log2FC),log2FC>2表示上调,log2FC<0.5表示上调。
2 结果与分析
2.1 红曲霉的分离纯化
3种红曲产品中共分离出5株红曲霉(图1),从南京同仁堂红曲米中分离出H1-1和H1-2;古田红曲米(颗粒状)中分离出H2-1;古田红曲米(粉末状)中分离出H3-1和H3-2。由图1可知,5种红曲霉菌株菌落形态相近,均为棉絮状,气生菌丝发达,呈放射状,随着培养时间延长,平板中会产生大量色素,中间突起,边缘整齐。在相同的培养时间下,菌株H2-1菌丝生长较为旺盛。
A-H1-1;B-H1-2;C-H2-1;D-H3-1;E-H3-2
图1 不同产品中红曲霉菌落形态
Fig.1 Colony morphology of Monascus in different products
2.2 抑菌效果
采用平板对峙法检测不同种类红曲中提取的红曲霉对A.niger抑菌效果,结果显示从红曲粉中提取的红曲霉抑菌效果强于红曲米中提取的红曲霉,其中H3-1抑菌效果最好(图2-D),两菌之间的抑菌带最宽,约为38.75 mm,A.niger生长范围最小;而从红曲米中提取的红曲霉(图2-A~图2-C)抑菌效果较差,两菌之间的抑菌带较小,A.niger丝生长范围广。
A-H1-1;B-H1-2;C-H2-1;D-H3-1;E-H3-2
图2 不同红曲霉拮抗病原真菌
Fig.2 Antagonism of pathogenic fungi by different Monascus
采用琼脂板打孔法检测红曲霉对S.aureus和E.coli的抑菌效果,结果显示从不同红曲产品中提取出的红曲内生菌的发酵液对病原细菌均无抑菌活性(图3)。

a-拮抗E.coli;b-拮抗S.aureus
图3 不同红曲霉拮抗病原细菌
Fig.3 Antagonism of pathogenic bacteria by different Monascus
注:A为H1-1,B为H1-2,C为H2-1,D为H3-1,E为H3-2。
综合以上抑菌结果,选取H3-1为目标菌株,进行后续菌株鉴定及代谢产物的研究等。
2.3 抗菌活性的复测
采用生长速率抑制法测定红曲霉H3-1的次生代谢产物对A.niger的抑菌活性。处理组样品质量浓度为20 mg/mL,以加等体积溶剂甲醇的平板为空白对照,抑菌结果如图4所示。结果显示,对照组平板A.niger 落厚,菌丝多且强壮,形成大量黑色孢子,而加入乙酸乙酯的处理组平板中只有极少部分生长出A.niger,抑菌率高达百分之85%,加入甲醇提取物的平板长满了A.niger,说明H3-1的代谢粗提物对A.niger 有很强的抑制作用,与初筛的结果相符合,根据MIC结果可知,H3-1代谢粗提物对A.niger的MIC为0.625 mg/mL,MBC为1.25 mg/mL。
A-加入溶剂甲醇的对照;B-加入乙酸乙酯提取物;C-加入甲醇提取物
图4 红曲霉H3-1代谢粗提物对A.niger的抑制作用
Fig.4 Inhibition of A.niger by crude metabolites of Monascus H3-1
2.4 红曲霉H3-1的菌种鉴定及系统进化分析
将红曲霉H3-1提取的DNA送往生工生物工程(上海)股份有限公司进行测序。结果表明可以获得片段大小为554 bp的明亮且单一的清晰条带(图5)。

图5 红曲霉H3-1扩增产物电泳图
Fig.5 Electropherogram of the amplified product of Monascus H3-1
待测菌株H3-1与已知明确种类的菌株序列同源性比对,将EF-1α基因序列和mtSSU基因联合后,与TF3、TF5、NRRL20 433等菌株序列分析后,分别使用MEGA 7.0软件采用邻接法(neighbor-joining,NJ)进行1 000次计算重复检验构建出系统发育树(图6)。采用EF-1α-mtSSU联合构建,结果表明菌株H3-1与Monascus处于同一分支上,结合形态特征和分子鉴定的结果,菌株H3-1可被鉴定为M.purpureus。

图6 基于EF-1α和mtSSU基因结合采用NJ法构建系统发育树
Fig.6 Phylogenetic tree construction based on the combination of EF-1α and mtSSU genes using the NJ method
2.5 代谢物成分检测结果
2.5.1 代谢物定性定量分析
QC样本由样本提取物混合制备而成,用于分析样本在相同的处理方法下的重复性。在仪器分析的过程中,一般每10个检测分析样本中插入一个质控样本,以监测分析过程的重复性。
通过对不同质控 QC样本质谱检测分析的总离子流图(图7)进行重叠展示分析,可以判断代谢物提取和检测的重复性,即技术重复。仪器的高稳定性为数据的重复性和可靠性提供了重要的保障。并对QC样本进行皮尔逊(Pearson)相关性分析(图8),QC样本相关性越高(r的绝对值越接近于1)说明整个检测过程稳定性越好,数据质量越高。横坐标为保留时间,纵坐标为该时间点采集到的信号最强的离子响应强度。图中色谱峰的响应强度和保留时间重叠度高,说明仪器检测过程的稳定性良好、数据质量良好。

图7 QC样本质谱检测TIC重叠图
Fig.7 TIC overlap diagram of QC sample mass spectrometry detection

图8 QC样本相关性图
Fig.8 QC sample correlation chart
2.5.2 代谢物检测结果
2.5.2.1 差异代谢物鉴定
经比较分析发现,红曲霉H3-1的乙酸乙酯提取物和甲醇提取物比较共有6 728种差异代谢物,其中下调1 935种,上调4 793种。PCA结果表明,红曲霉H3-1乙酸乙酯提取和甲醇提取的代谢产物之间存在显著差异,但组内没有显著差异,说明本次实验的稳定性较好(图9-A)。将不同萃取剂中所检测到的代谢物进行聚类分析,表明红曲霉H3-1经乙酸乙酯和甲醇提取之间的代谢物含量存在明显差异(图9-C)。

A-红曲霉代谢产物PCA结果;B-红曲霉不同提取方法差异代谢物分类;C-红曲霉不同提取方法差异代谢物聚类热图; D-差异变化上下调各前10物质含量差异动态分布图(H1YSYZ表示乙酸乙酯提取物组,H1CK表示甲醇提取物组)
图9 红曲霉H3-1乙酸乙酯提取和甲醇提取代谢物鉴定情况
Fig.9 Identification of ethyl acetate extracted and methanol extracted metabolites of Monascus H3-1
对代谢物进行分类发现代谢物主要为氨基酸及其代谢物1 313种和苯及其衍生物1 172种,分别占总代谢物的20%和17%,还包括杂环化合物861种、醇酮酯类686种、有机酸及其衍生物596种、甘油磷脂类325种、醇胺类209种、脂肪酸类252种和其他类377种等(图9-B)。上调前10种代谢物为N-油酰基甘氨酸、甲基孕酮、葡糖神经酰胺、肉碱C18:1、L-精氨酰-L-组氨酰-L-谷氨酰胺、天冬酰胺-精氨酸-谷氨酰胺-赖氨酸、视黄醛、异石胆酸、左炔诺孕酮、6,8a-Seco-6,8a-deoxy-5-oxoavermectin“2b”糖苷配基,下调前10种代谢物为扎托洛芬、d[-Arg-2]京托潘、2,4-二乙酰基间苯三酚、L-亮氨酰甘氨酰甘氨酸、rac-4-hydroxy-4-O-(beta-D-glucuronide)-all-trans-retinyl acetate、5-甲氧基色氨酸、硫醇盐、油酰基乙酰胺、异戊二烯醇二糖苷、硬脂酰甘油磷酸酯(图9-D)。
2.5.2.2 主要差异代谢物分析
为进一步明确红曲霉代谢产物中的抑菌活性成分,选取差异代谢物中含量前30位的代谢物进一步分析(表1)。
表1 乙酸乙酯和甲醇提取物前30位差异代谢物统计
Table 1 Statistics of the top 30 differential metabolites of ethyl acetate and methanol extracts

序号代谢物代谢物分类样本相对含量差值差异倍数1N-油酰基甘氨酸氨基酸及其代谢物17 079.9417.002甲基孕酮激素及激素相关物质84 583.2715.653 葡糖神经酰胺鞘脂类89 103.2314.604肉碱 C18:1脂肪酰类 40 955.72 14.425L-精氨酰-L-组氨酰-L-谷氨酰胺氨基酸及其代谢物141 910 633.3113.246天冬酰胺-精氨酸-谷氨酰胺-赖氯酸氨基酸及其代谢物3 655 437 747.5913.117视黄醛辅酶和维生素 24 473.7513.098异石胆酸胆汁酸2 138 835.65 12.519左炔诺孕酮激素及激素相关物质 262 095.3012.24106,8a-Seco-6,8a-deoxy-5-oxoavermectin“2b”糖苷配基醛、酮、酯类 2 699 818.1311.9311PE-NMe2[16:1(9Z)/18:0]甘油磷脂类3 098.0111.9212去吗啡生物碱947 376 064.7011.82131,2-二十五碳烯基-sn-甘油-3-磷酸胆碱 甘油磷脂类6 283.06 11.78142-二十二碳六烯酰基-1-硬脂酰基-sn-甘油-3-磷酸乙醇胺 甘油磷脂类3 810 110.1411.7615L-异亮氨酸-L-苯丙氨酸-L-精氨酸氨基酸及其代谢物1 606 471 743.2011.7016伽马法加林杂环化合物 1 185 405.8811.5917二十四碳八烯酸脂肪酰类7 173 658 551.0811.4918脯氨酸-天冬酰胺-谷氨酰胺-甲硫氨酸-丝氨酸氨基酸及其代谢物6 564 268.7311.44194-硝基苯酚苯及其衍生物 351 639.1011.04202,6-二羟基苯甲酸苯及其衍生物349 689 790.3710.9921thiophen-3-ylmethyl (5Z,8Z,11Z,14Z)-icosa-5,8,11,14-tetraenoate脂肪酰类115 243.1110.9022(20R,22R)-20,22-二羟基胆固醇醇、胺类 13 202 287.6910.87233,4-二氢-5-丙酰基-2H-吡咯杂环化合物475 226 227.76 10.8124PC[22:0/20:3(5Z,8Z,11Z)]甘油磷脂类186 309 461.24 10.7925芬戈莫德苯及其衍生物 50 794 740.36 10.7626 PE-NMe2[20:0/18:2(9Z,12Z)]甘油磷脂类283 834 269.6410.7227缬氨酸-丙氨酸-组氨酸-谷氨酸氨基酸及其代谢物65 670 996.7810.6728色氨酸-谷氨酰胺-天冬酰胺氨基酸及其代谢物11 596 215.1110.6129天冬氨酸-脯氨酸-赖氨酸氨基酸及其代谢物32 524 823 937.3110.6130天竺葵素黄酮165 759 184.0210.53
结果表明,前30种代谢物共可分为13类,其中氨基酸及其代谢物类9种、甘油磷脂类5种、苯及其衍生物类3种、脂肪酰类3种、杂环化合物类2种、激素及激素相关物质类2种、生物碱类、醛、酮、酯类、鞘脂类、黄酮类、辅酶和维生素类、胆汁酸类和醇、胺类各1种。其N-油酰基甘氨酸和L-精氨酰-L-组氨酰-L-谷氨酰胺等氨基酸及其代谢物占比最高,高达30%,可能是红曲霉代谢产物产生抑菌活性的主要成分。
3 结论与讨论
通过对3种不同的红曲产品的红曲霉进行分离纯化及鉴定,最终共分离得到5株红曲霉菌株:H1-1、H1-2、H2-1、H3-1、H3-2,其菌落初期形态特征表现为白色,后期因分泌色素而变为橙红色。通过平板对峙法检测5株红曲霉对A.niger的抑菌活性,结果显示红曲霉H3-1对A.niger抑制效果最好,经鉴定该菌为M.purpureus。
用乙酸乙酯提取的红曲霉H3-1发酵的次生代谢产物也表现出良好的抑菌效果,而甲醇提取物却无抑菌活性,通过非靶向代谢组学分析发现,乙酸乙酯提取物和甲醇提取物的差异代谢物中氨基酸及其代谢物含量最高,且为红曲霉H3-1的主要代谢产物。A.niger的氨基酸代谢通路在其生长和代谢产物合成中起着重要作用,强化或抑制特定氨基酸的合成途径,可影响A.niger的生长和产酶能力[12]。孙晶[13]通过基因工程技术构建了A.niger的基因缺失菌株,研究了与氨基酸代谢相关的基因(如ubc7基因)对A.niger生长和外源蛋白表达的影响,表明调控氨基酸代谢通路可以显著抑制A.niger的生长。成宝琨[14]构建了A.niger的代谢控制论模型,重点分析了氨基酸代谢通路在A.niger生长和代谢中的作用,发现通过干预氨基酸代谢通路,可以有效抑制A.niger的生长。甘氨酸和L-谷氨酸(Glu)在生物体内的氨基酸代谢过程中占据重要地位,研究发现锁掷酵母CC-HS1可通过抑制A.niger氨基酸代谢来抑制其生长,并且证明了甘氨酸可有效提升其抗菌能力[15]。杨佳丽等[16]在梨病变部位加入100~1 000 μg/mL Glu,24~36 h后,可以显著降低梨果实青霉病的发病率及病斑直径。此外,差异代谢物中的苯及其衍生物数量也较多,这类物质也通常表现出良好的抑菌活性[17]。而肉桂醛和丁香酚等苯类衍生物大多数具有苯环和共轭双键结构,这些结构可使活性电子转移,与微生物细胞膜表面上的离子通道蛋白的相互作用,从而改变细胞膜的渗透性并导致细胞质的渗漏,减少微生物的生长[18]。姜楠[19]研究发现丁香酚可以显著抑制葡萄果实上炭黑曲霉的生长,并且50 mmol/L丁香酚即可完全抑制OTA毒素的产生。王新伟等[20]研究表明牛至油、香芹酚、柠檬醛、肉桂醛对A.niger 均有抑制作用。而紫檀芪作为有效的的抗菌剂,不仅能够抑制葡萄汁中炭黑曲毒的生长而且可以减少赭曲霉毒素A的产生[21]。上述苯类衍生物在乙酸乙酯提取的代谢产物中的含量明显高于甲醇提取物,抑菌效果的差异可能就是由这些物质的变化产生。此外,多篇文章报道了酚酸类物质阿魏酸对A.niger 的抑制作用,张微微等[22]研究发现质量分数为0.6%的阿魏酸对霉菌的抑菌效果显著,其抑菌机理可能是通过延长指示菌株的适应期,破坏蛋白质的合成,影响指示菌株对培养基的利用能力,从而干扰菌株生理代谢活动。阿来·海拉希等[23]研究指出,阿魏酸可抑制A.niger等致病菌,当阿魏酸提取物的质量分数为0.6%时,对青霉和A.niger的抑制效果比较显著,抑菌效果也随着抑菌浓度的增加和时间的延长而越发显著。
本研究从红曲产品中分离、鉴定到1株M.purpureus,其乙酸乙酯提取的次生代谢产物对A.niger的抑制效果比较显著,其中氨基酸及其代谢物和苯及其衍生物可能为乙酸乙酯和甲醇2种不同萃取剂提取的代谢物抗菌活性差异的主要原因,甘氨酸、L-谷氨酸、肉桂醛、丁香酚等可能是抑制A.niger的主要活性物质,研究结果为红曲霉的新产品的开发利用提供了理论依据。
[1] 李志强, 刘颖, 林风, 等.福建古田红曲生产用红曲霉菌主要种类的鉴别[J].食品与发酵工业, 2017, 43(5):64-69.LI Z Q, LIU Y, LIN F, et al.Identification of major Monascus sp.involved in industrial production of Gutian Hongqu[J].Food and Fermentation Industry, 2017, 43(5):64-69.
[2] 潘荣华, 方章昀, 唐心怡, 等.红曲霉二次代谢产物及其药理作用的研究进展[J].华西药学杂志, 2023, 38(3):345-351.PAN R H, FANG Z Y, TANG X Y, et al.Research progress on secondary metabolites of Monascus spp.and their pharmacological activities[J].West China Journal of Pharmacy,2023,38(3):345-351.
[3] ENDO A.Monacolin K, a new hypocholesterolemic agent produced by a Monascus species [J].The Journal of Antibiotics, 1979, 32(8):852-854.
[4] ALBERTS A W, CHEN J, KURON G, et al.Mevinolin:A highly potent competitive inhibitor of hydroxymethylglutaryl-coenzyme A reductase and a cholesterol-lowering agent[J].Proceedings of the National Academy of Sciences of the United States of America, 1980, 77(7):3957-3961.
[5] DUPONT A G, LÉGAT L.GABA is a mediator of brain AT1 and AT2 receptor-mediated blood pressure responses[J].Hypertension Research, 2020, 43(10):995-1005.
[6] NOZAKI H , DATE S , KONDO H ,et al. Ankalactone, a new α, β -unsaturated γ -lactone from Monascus anka[J]. Agricultural &Biological Chemistry, 1991, 55(3):899-900.
[7] 刘书渊, 陈骐, 杨晓暾, 等.红色红曲霉Mr-1的次级代谢产物生物活性成分分析[J].微生物学通报, 2021, 48(3):787-796.LIU S Y, CHEN Q, YANG X T, et al.Bioactive components of secondary metabolites from Monascus ruber Mr-1[J].Microbiology Bulletin,2021, 48(3):787-796.
[8] CHULYOUNG K, HEEYONG J, OOK K Y, et al.Antimicrobial activities of amino acid derivatives of Monascus pigments[J].Fems Microbiology Letters, 2010, (1):11.
[9] MART NKOV
NKOV L, J°ZLOV
L, J°ZLOV P,
P, ![]() D.Biological activity of polyketide pigments produced by the fungus Monascus[J].Journal of Applied Bacteriology, 1995,79(6):609-616.
D.Biological activity of polyketide pigments produced by the fungus Monascus[J].Journal of Applied Bacteriology, 1995,79(6):609-616.
[10] 张红林.福建古田红曲米天然产物的分离纯化、结构鉴定与活性研究[D].厦门:集美大学, 2018.ZHANG H L.Purification, identification and activity study of natural product from gutian red yeast rice in fujian[D].Xiamen:Jimei University, 2018.
[11] 唐梓宁, 陈相池, 刘学武, 等.免疫抑制介导大鼠侵袭性黑曲霉菌肺病模型的构建与评价[J].中国比较医学杂志, 2024, 34(6):63-72.TANG Z N, CHEN X C, LIU X W, et al.Construction and evaluation of an immunosuppression-mediated model of invasive Aspergillus niger lung disease in rats[J].Chinese Journal of Comparative Medicine, 2024, 34(6):63-72.
[12] 曹玮强. 黑曲霉产糖化酶发酵过程多组学分析及基于强化氨基酸合成途径的产酶代谢工程探索[D].上海:华东理工大学, 2020.CAO W Q.Multi-omics integrative analysis of Aspergillus niger fermentation process for glucoamylase production and exploration on metabolic engineering of enzyme producation based on enhancing amino acid synthetic pathway[D].Shanghai:East China University of Science and Technology, 2020.
[13] 孙晶. 黑曲霉基因缺失菌株的构建及其功能分析[D].黑龙江:东北农业大学, 2004.SUN J.Construction and functional analysis of gene disruptant in Aspergillus niger[D].Heilongjiang:Northeast Agricultural University, 2004.
[14] 成宝琨. 整合组学分析的黑曲霉代谢控制论模型研究[D].上海:上海交通大学, 2015.CHENG B K.A cybernetic model coupled with omics information for citric acid fermentation by Aspergillus niger[D].Shanghai:Shanghai Jiao Tong University, 2015.
[15] 高倩. 锁掷酵母对苹果采后致腐黑曲霉的抑制作用及机制研究[D].长春:吉林大学, 2023.GAO Q.Study on the inhibition effect and mechanism of Sporidiobolus pararoseus on rot-causing Aspergillus niger in postharvest[D].Changchun:Jilin University, 2023.
[16] 杨佳丽, 余挺, 余辰杨佳丽, 余挺, 余辰, 等. L-谷氨酸对梨果实青霉病的诱导抗性初探[C]. 中国食品科学技术学会第十一届年会论文摘要集. 杭州:中国食品科学技术学会, 2014:314-315.YANG J L, YU T, YU C, et al. Preliminary study of L-glutamic treatment induces resistance to Penicillium expansum in pear fruit[C]. Abstracts of the 11th Annual Conference of the Chinese Society for Food Science and Technology. Hangzhou: Chinese Society of Food Science and Technology, 2014: 314-315.
[17] 贾淑红. 苯并咪(噻、噁)唑衍生物合成及抗菌活性研究[D].新乡:河南师范大学,2017.JIA S H.Synthesis and antimicrobial activity of benzimidazole,benzimidazole and benzoxazole derivatives [D].Xinxiang:Henan Normal University,2017.
[18] 李凤清. 植物精油的抑菌评价及其应用[D].南京:南京师范大学, 2014.LI F Q.Antibacterial evaluation and application of plant essential oil[D].Nanjing:Nanjing Normal University, 2014.
[19] 姜楠. 丁香酚对炭黑曲霉及赭曲霉毒素A的抑制及葡萄品质提升[D].无锡:江南大学, 2024.JIANG N.Inhibition of eugenol to Aspergillus carbonarius and ochratoxin A and improvement of grape quality[D].Wuxi:Jiangnan University, 2024.
[20] 王新伟, 杜会云, 宋玉函, 等.牛至油、香芹酚、柠檬醛和肉桂醛抗真菌研究[J].食品科技, 2011, 36(2):193-196;202.WANG X W, DU H Y, SONG Y H, et al.Antimicrobial activity of oregano ossential oil, carvacrol, citral and cinnamaldehyde[J].Food Science and Technology, 2011, 36(2):193-196;202.
[21] 任雪艳, 祁建蕊, 孔庆军. 紫檀芪在抑制葡萄汁中炭黑曲霉生长及赭曲霉毒素A产生的应用: 中国,CN201811649476[P]. 2022-03-18.REN X Y, QI J R, KONG Q J. The application of pterostilbene in inhibiting the growth of Aspergillus carbonarius and the production of ochratoxin A in grape juice: China,CN201811649476[P]. 2022-03-18.
[22] 张微微, 马莹, 袁媛, 等.阿魏酸对青贮主要有害微生物作用效果及机理研究[J].中国饲料, 2021(7):28-32.ZHANG W W, MA Y, YUAN Y, et al.Effect and mechanism of ferulic acid on major microorganisms in silage[J].China Feed, 2021(7):28-32.
[23] 阿来·海拉希, 德丽达·木拉提别克, 迪丽努尔·马力克.阿魏中阿魏酸的提取方法及抑菌作用研究[J].当代化工, 2017, 46(12):2454-2459.ALAI Hi,DELIDA M,DILINUER M.Study on extraction methods and antibacterial activity of ferulic acid from ferula asafoetida[J].Contemporary Chemical Industry,2017,46(12):2454-2459.